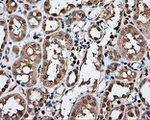
APP Antibody in Immunohistochemistry (Paraffin) (IHC (P))

Search
OriGene
APP Monoclonal Antibody (OTI2B10), TrueMAB™
{{$productOrderCtrl.translations['antibody.pdp.commerceCard.promotion.promotions']}}
{{$productOrderCtrl.translations['antibody.pdp.commerceCard.promotion.viewpromo']}}
{{$productOrderCtrl.translations['antibody.pdp.commerceCard.promotion.promocode']}}: {{promo.promoCode}} {{promo.promoTitle}} {{promo.promoDescription}}. {{$productOrderCtrl.translations['antibody.pdp.commerceCard.promotion.learnmore']}}
产品信息
TA500973
种属反应
宿主/亚型
分类
类型
克隆号
抗原
偶联物
形式
浓度
纯化类型
保存液
内含物
保存条件
运输条件
靶标信息
Amyloid Precursor Protein (APP) or Amyloid beta precursor protein functions as a cell surface kinesin I membrane receptor, mediating the axonal transport of beta-secretase and presenilin 1. APP is important for neurite growth, neuronal adhesion and axonogenesis. APP is a 100-140 kDa transmembrane glycoprotein that exists as several isoforms resulting from alternative splicing. Proteolytic cleavage of APP by beta- and gamma-secretases results in the generation of beta amyloid, which is the primary component of senile plaques. Senile plaques are one of the major histopathologic features of Alzheimer's disease. Abnormal regulation and processing of APP also plays a role in Down's syndrome, early onset familial Alzheimer's disease, and cerebral hemorrhage.
仅用于科研。不用于诊断过程。未经明确授权不得转售。
篇参考文献 (0)
生物信息学
蛋白别名: ABPP; Alzheimer disease amyloid A4 protein homolog; Alzheimer disease amyloid protein; Amyloid b precursor protein; amyloid beta (A4) precursor protein; Amyloid precursor protein; Amyloid β precursor protein; Amyloid-beta (A4) precursor protein; Amyloid-beta A4 protein; Amyloid-beta precursor protein; APP; APPI; beta-amyloid peptide; beta-amyloid peptide(1-40); beta-amyloid peptide(1-42); beta-amyloid precursor protein; Cerebral vascular amyloid peptide; CVAP; Pan-Abeta; peptidase nexin-II; PN-II; PreA4; Protease nexin-II; testicular tissue protein Li 2
基因别名: A4; AAA; ABETA; ABPP; AD1; APP; APPI; CTFgamma; CVAP; PN-II; PN2
UniProt ID: (Human) P05067
Entrez Gene ID: (Human) 351